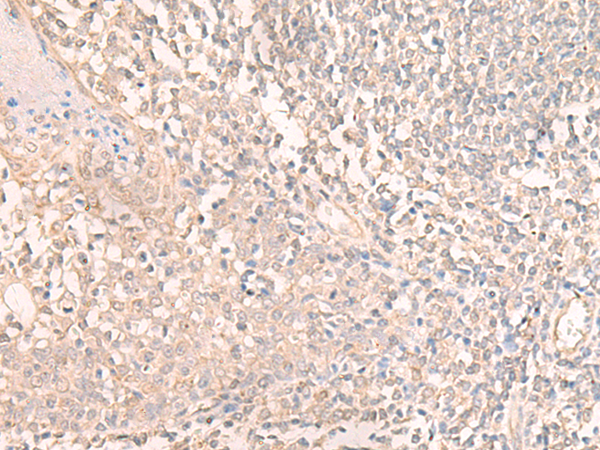

-
分类: 科研抗体货号: P13319别名:应用: IHC反应种属: Human, Mouse
-
分类: 科研抗体货号: P13301别名: M1Pi; MRDI; MTNA; Ypr118w应用: WB,IHC反应种属: Human
-
分类: 科研抗体货号: P13284别名:应用: IHC反应种属: Human, Mouse, Rat
-
分类: 科研抗体货号: P13318别名: DERP7; DNAPTP4应用: IHC反应种属: Human
-
分类: 科研抗体货号: P13300别名: CG1; EHM2应用: IHC反应种属: Human
-
分类: 科研抗体货号: P13283别名: RNF19应用: IHC反应种属: Human, Mouse
-
分类: 科研抗体货号: P13317别名:应用: WB反应种属: Human
-
分类: 科研抗体货号: P13299别名: PAST3应用: WB,IHC反应种属: Human, Mouse, Rat
-
分类: 科研抗体货号: P13310别名:应用: IHC反应种属: Human, Mouse
-
分类: 科研抗体货号: P13316别名: GL002; C11orf30应用: IHC反应种属: Human, Mouse

鄂公网安备42018502007531号
鄂公网安备42018502007531号

